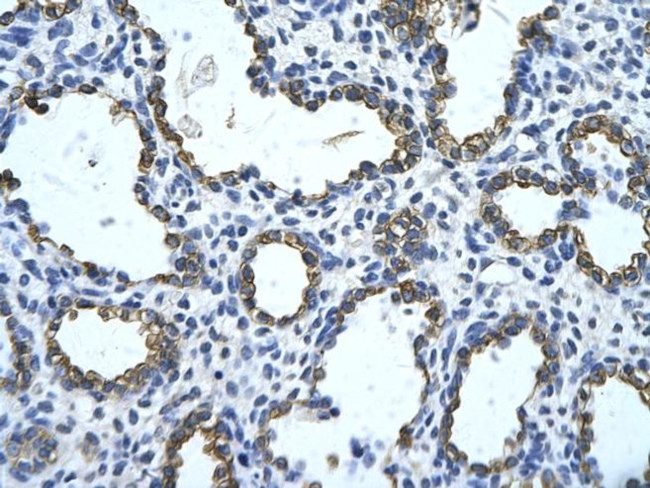
GNAS Antibody in Immunohistochemistry (Paraffin) (IHC (P))

Search
Invitrogen
GNAS Polyclonal Antibody
{{$productOrderCtrl.translations['antibody.pdp.commerceCard.promotion.promotions']}}
{{$productOrderCtrl.translations['antibody.pdp.commerceCard.promotion.viewpromo']}}
{{$productOrderCtrl.translations['antibody.pdp.commerceCard.promotion.promocode']}}: {{promo.promoCode}} {{promo.promoTitle}} {{promo.promoDescription}}. {{$productOrderCtrl.translations['antibody.pdp.commerceCard.promotion.learnmore']}}
产品信息
PA5-42230
种属反应
宿主/亚型
分类
类型
抗原
偶联物
形式
浓度
规格
纯化类型
保存液
内含物
保存条件
运输条件
RRID
产品详细信息
Peptide sequence: SGKSTIVKQM RILHVNGFNG DSEKATKVQD IKNNLKEAIE TIVAAMSNLV
Sequence homology: Cow: 93%; Human: 100%; Mouse: 100%; Pig: 100%; Rabbit: 93%; Rat: 100%
靶标信息
Mutations in GNAS gene result in pseudohypoparathyroidism type 1a, pseudohypoparathyroidism type 1b, Albright hereditary osteodystrophy, pseudopseudohypoparathyroidism, McCune-Albright syndrome, progressive osseous heteroplasia, polyostotic fibrous dysplasia of bone, and some pituitary tumors. This gene has a highly complex imprinted expression pattern. It encodes maternally, paternally, and biallelically expressed proteins which are derived from alternatively spliced transcripts with alternate 5' exons. Each of the upstream exons is within a differentially methylated region, commonly found in imprinted genes. However, the close proximity (14 kb) of two oppositely expressed promoter regions is unusual. In addition, one of the alternate 5' exons introduces a frameshift relative to the other transcripts, resulting in one isoform which is structurally unrelated to the others. An antisense transcript exists, and may regulate imprinting in this region. Mutations in this gene result in pseudohypoparathyroidism type 1a (PHP1a), which has an atypical autosomal dominant inheritance pattern requiring maternal transmission for full penetrance.
仅用于科研。不用于诊断过程。未经明确授权不得转售。
篇参考文献 (0)
生物信息学
蛋白别名: Adenylate cyclase-stimulating G alpha protein; Alternative gene product encoded by XL-exon; dJ309F20.1.1; dJ806M20.3.3; Extra large alphas protein; G protein; G protein subunit alpha S; GNSA1; Gs alpha subunit; guanine nucleotide binding protein (G protein), alpha stimulating activity polypeptide 1; guanine nucleotide regulatory protein; guanine nucleotide-binding protein alpha subunit; Guanine nucleotide-binding protein G(s) subunit alpha isoforms short; Guanine nucleotide-binding protein G(s) subunit alpha isoforms XLas; MGC33735; NESP55; NESP55; large dense core vesicle secretory protein; Neuroendocrine secretory protein 55; OTTHUMP00000031742; OTTHUMP00000196026; OTTHUMP00000196030; PHP1C; Protein ALEX; RP4-543J19.4; secretogranin VI; stimulatory G-protein alpha subunit; unnamed protein product; XLalphas; XLas
基因别名: 5530400H20Rik; A930027G11Rik; AHO; AIMAH1; C130027O20Rik; C20orf45; Galphas; GNAS; GNAS1; Gnasxl; GPSA; GSA; GSP; MNCb-5546; NESP; Nespl; Oed-Sml; Oedsml; P1; P2; P3; PHP1A; PHP1B; PITA3; POH; SCG6; SgVI
UniProt ID: (Human) Q5JWF2, (Mouse) Q6R0H7
Entrez Gene ID: (Human) 2778, (Mouse) 14683